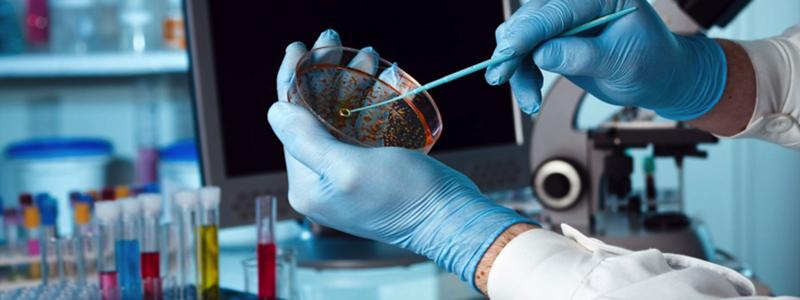
Beriberi hastalığı nedir

Genelde Asya'da görülen bu rahatsızlık, çok kısıtlı beslenen kişilerde de ortaya çıkar. Beriberi hastalığında beyin, sinirler ve kaslar (kalp kası da dahil) işlevini yerine getiremez.

BESLENMENİN DÜZELTİLMESİ GEREKİR
Kuru beriberi hastalığı ve ıslak beriberi hastalığı olarak ikiye ayrılan bu hastalık tam anlamıyla tedavi edilebilir. Bu yüzden beslenmenin de kalıcı şekilde düzeltilmesi gerekir.